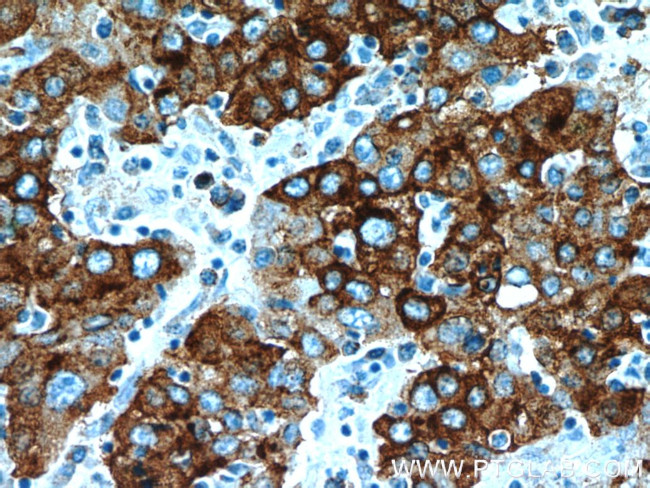
B3GALT6 Antibody in Immunohistochemistry (Paraffin) (IHC (P))
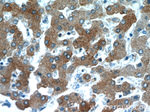
B3GALT6 Antibody in Immunohistochemistry (Paraffin) (IHC (P))

Search
Proteintech
B3GALT6 Polyclonal Antibody
{{$productOrderCtrl.translations['antibody.pdp.commerceCard.promotion.promotions']}}
{{$productOrderCtrl.translations['antibody.pdp.commerceCard.promotion.viewpromo']}}
{{$productOrderCtrl.translations['antibody.pdp.commerceCard.promotion.promocode']}}: {{promo.promoCode}} {{promo.promoTitle}} {{promo.promoDescription}}. {{$productOrderCtrl.translations['antibody.pdp.commerceCard.promotion.learnmore']}}
产品信息
55049-1-AP
种属反应
宿主/亚型
分类
类型
抗原
偶联物
形式
浓度
规格
纯化类型
保存液
内含物
保存条件
运输条件
产品详细信息
The antibody is specific to B3GALT6.
靶标信息
B3GALT6, Beta-1, 3-galactosyltransferase that transfers galactose from UDP-galactose to substrates with a terminal beta-linked galactose residue. B3GALT6 has a preference for galactose-beta-1, 4-xylose that is found in the linker region of glycosaminoglycans, such as heparan sulfate and chondroitin sulfate. B3GALT6 has no activity towards substrates with terminal glucosamine or galactosamine residues.
仅用于科研。不用于诊断过程。未经明确授权不得转售。
篇参考文献 (0)
生物信息学
蛋白别名: Beta-1,3-galactosyltransferase 6; Beta-1,3-GalTase 6; beta3Gal-T6; beta3GalT6; GAG GalTII; Galactosyltransferase II; Galactosylxylosylprotein 3-beta-galactosyltransferase; UDP-Gal:betaGal beta 1,3-galactosyltransferase 6; UDP-Gal:betaGal beta 1,3-galactosyltransferase polypeptide 6; UDP-Gal:betaGlcNAc beta 1,3-galactosyltransferase, polypeptide 6
基因别名: ALGAZ; B3GALT6; BB129894; beta3GalT6; EDSP2; EDSSPD2; GalTII; SEMDJL1
UniProt ID: (Human) Q96L58, (Mouse) Q91Z92
Entrez Gene ID: (Human) 126792, (Mouse) 117592